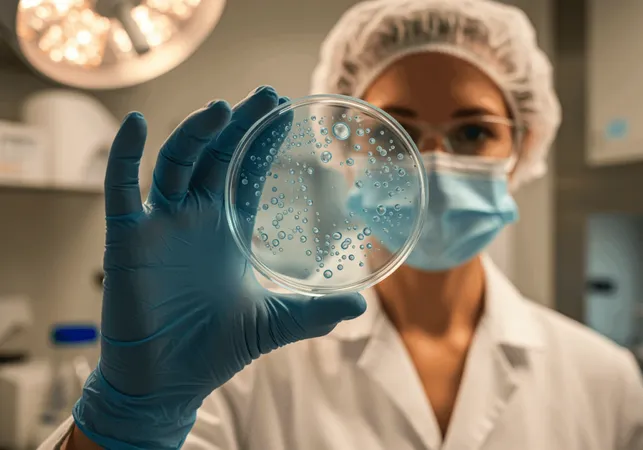
Freepik Candid Photography With Natural Textures And Highl X - Certified Cytotechnologist study guide

CT (Certified Cytotechnologist) Test Guide
Gain insight into the CT (Certified Cytotechnologist) profession, including career pathways, training requirements, salary expectations, and job opportunit


A CT (Certified Cytotechnologist) is a healthcare professional trained to examine cells and tissues to detect abnormalities that may indicate cancer or other diseases. These experts play a vital role in pathology laboratories, assisting physicians in diagnosing patients through microscopic cellular analysis. Becoming a certified cytotechnologist can lead to a rewarding career, with numerous opportunities in medical laboratories, hospitals, and research institutions. This guide covers essential information about the profession, including salary expectations, job roles, educational requirements, training programs, and the certification process.
Key Takeaways
Free Cytotechnologist Practice Test Online
- Certified cytotechnologists play a crucial role in healthcare, assisting with the diagnosis of diseases by examining cells and tissues microscopically.
- The average salary for cytotechnologists varies by experience, specialization, and geographic location, with opportunities for advancement.
- To become a cytotechnologist, individuals need to complete a relevant bachelor’s degree, attend an accredited cytotechnology program, and pass the ASCP certification exam.
- Opportunities for cytotechnologists exist across diverse settings, including hospitals, research facilities, and government agencies.
- Continuing education is essential for certification renewal and staying updated with advancements in cellular pathology.
FREE CT Cytopreparation Techniques Questions and Answers
Free Certified Cytotechnologist practice test covering free ct cytopreparation techniques questions and answers. Prepare for the exam with targeted practice questions.
FREE CT Education & Communication Questions and Answers
Certified Cytotechnologist exam practice questions on free ct education & communication questions and answers. Test your knowledge and boost your confidence.
FREE CT Interpretation of Cytologic Material Questions and Answers
Practice Certified Cytotechnologist questions focusing on free ct interpretation of cytologic material questions and answers. Essential review for your certification exam.
FREE CT Laboratory Operations Questions and Answers
Certified Cytotechnologist test prep covering free ct laboratory operations questions and answers. Master key concepts and improve your exam readiness.

Cytotechnologist Salary
The salary for a certified cytotechnologist can vary based on location, experience, and the type of healthcare setting in which they work. Here’s a breakdown of factors influencing cytotechnologist compensation:
- National Average Salary: According to the Bureau of Labor Statistics, cytotechnologists can expect an average annual salary in the range of $60,000 - $80,000, though this can fluctuate.
- Experience Level: Entry-level cytotechnologists typically start on the lower end of the salary spectrum, while those with extensive experience, or who work in specialized fields, can earn significantly more.
- Location-Based Variation: Cytotechnologists in urban or high-demand areas, such as large hospitals in metropolitan centers, may receive higher salaries than those in rural areas.
- Specialized Roles: Cytotechnologists with advanced certifications or expertise in a particular type of testing may be compensated at a higher rate.
Cytotechnologist Job Opportunities
Cytotechnologists are in demand due to the critical nature of their work in diagnosing and preventing disease. Their skills make them valuable in various healthcare and research settings, including:
- Hospitals and Clinics: Many cytotechnologists work in pathology departments, supporting oncologists and other specialists in identifying cancerous cells and other abnormalities.
- Research Facilities: Some cytotechnologists contribute to medical research, analyzing cellular data to advance the understanding of diseases.
- Government Health Agencies: Positions with public health departments and agencies like the Centers for Disease Control and Prevention (CDC) offer cytotechnologists unique career pathways with a focus on community health.
- Academic Institutions: Universities and teaching hospitals often employ cytotechnologists in research and educational capacities.
Cytotechnologist Training and Education Programs
The journey to becoming a certified cytotechnologist begins with specialized education. Here’s what prospective cytotechnologists need to know about training and program requirements:
- Educational Requirements: Most cytotechnologists hold a bachelor's degree in cytotechnology or a related field such as biology, microbiology, or biomedical sciences.
- Accredited Cytotechnology Programs: Aspiring cytotechnologists should seek programs accredited by the Commission on Accreditation of Allied Health Education Programs (CAAHEP), which ensures a comprehensive curriculum that includes lab techniques, cellular pathology, and clinical rotations.
- Advanced Studies: Some cytotechnologists pursue a master’s degree to enhance their career opportunities or specialize in research, which may lead to higher pay or teaching positions.
- Hands-on Training: Accredited programs include supervised clinical experiences, typically completed in hospital or clinical laboratories, where students gain practical skills needed for certification exams.
Cytotechnologist Certification and Licensing
Becoming certified as a cytotechnologist involves meeting specific qualifications and passing examinations designed to validate expertise and knowledge. Here’s an overview of the certification and licensing process:
- Certification Exam: After completing an accredited program, candidates are eligible to take the certification exam administered by the American Society for Clinical Pathology (ASCP). The CT (ASCP) certification is a widely recognized credential that demonstrates proficiency.
- State Licensing: Certain states require cytotechnologists to obtain a license. While not all states have this requirement, candidates should research local regulations to ensure compliance.
- Continuing Education: Maintaining certification typically requires ongoing professional development. The ASCP mandates periodic continuing education for recertification, helping cytotechnologists stay up-to-date with advances in cellular pathology.
Steps to Become a Cytotechnologist
If you’re considering a career as a cytotechnologist, here are the steps you’ll need to follow to achieve certification and enter the field:
- Earn a Bachelor’s Degree: Start by obtaining a bachelor’s degree in cytotechnology, biology, or a related discipline. This foundational education is essential for advanced study in cytotechnology.
- Complete an Accredited Cytotechnology Program: Apply to an accredited cytotechnology program that includes laboratory training and clinical rotations to gain practical experience.
- Pass the ASCP Certification Exam: Upon completion of your program, you’ll be eligible to sit for the ASCP certification exam, which qualifies you to work as a certified cytotechnologist.
- Meet State Licensing Requirements: Verify any additional licensing requirements that may apply in your state to ensure compliance.
- Pursue Continuing Education: Maintaining certification and staying current in the field often requires continuing education, which can also open up advanced career opportunities.

Conclusion
A career as a certified cytotechnologist offers unique opportunities in the healthcare field, where these professionals contribute significantly to patient diagnosis and disease prevention. With a solid educational foundation, certification, and dedication to continuous learning, cytotechnologists can look forward to a fulfilling career in various medical and research environments. Whether working directly with patient samples in a hospital or advancing disease research in a lab, certified cytotechnologists are integral to the healthcare system.
For anyone passionate about science and helping others, becoming a cytotechnologist is a rewarding choice with ample career prospects.